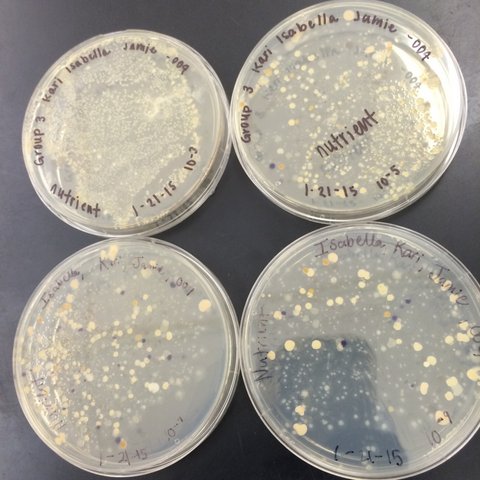

User:Kari Anna Byrnes/Notebook/Biology 210 at AU
Lab #6 Zebrafish and Caffeine
March 20, 2015 - KB
Purpose
The purpose of this lab was to learn the stages of embryonic development. In addition, the purpose was to study the effects of caffeine on embryonic development.
Materials and Methods
A hypothesis, prediction, and experimental plan was made after reading a published paper about the effect on zebrafish development. Caffeine was the independent variable for the experiment. First, a control group was made by pouring 20 mLs of deerpark water into a petri dish. The experimental group was made by pouring a diluted caffeine solution into a different petri dish. Next, 20 healthy translucent embryos were placed in each of the two dishes, making 40 zebrafish total. An observation schedule was made, along with a table displaying the progression of the zebrafish development. The zebrafish observations were recorded every Monday, Wednesday, and Friday for two weeks. To observe the fish, they were placed in a depression slide and observed through a microscope. Suggested observations included factors such as movement, heart rate, live fish, dead fish, dead eggs, live hatchlings, eye movement, pectoral fin development, yolk sac size, swim bladder development, and mouth development. After four days, their water was changed by removing 10 mL, the dead zebrafish, and debris, and adding 25 mL of fresh water (control petri dish) and caffeinated water (experimental petri dish). The changing of water occurred again on day 7 and 14 of the experiment. Each time, one dead embryo from each dish was saved in paraformaldehyde for later observation. After day 7, the zebrafish were fed with two drops of paramecium each time the water was changed. Final observations were made on Day 14 and survivors were placed in an aquarium for safe keeping.
Data and Observations
Due to a host of moldy zebrafish, two days were lost in the laboratory, shortening the study to 12 days total. Throughout the study, there were major differences between the control and experimental groups. The caffeinated environment made the zebrafish have faster heart rates, an arched body, a higher death rate, darker pigmentation, a shorter body length, slower movement, and overall weakness. These differences did not arise until Day 8 of the study, once the fish were over 72 hours old.
Table 1. This table includes the observations and data collected throughout the 12 days of the study. It compares the control group to the test group. Movement values are based on slowest to fastest movement, in comparison to the control zebrafish on day 6.
Table 2. (continuation) This table includes the observations and data collected throughout the 12 days of the study. It compares the control group to the test group.
Figure 1. Photo of the control zebrafish on day 6
Figure 2. Photo of the treatment zebrafish on day 6
Conclusions and Future Directions
The data collected throughout the study suggests that caffeine has an effect on the embryonic development on zebrafish. The effect is not favorable for the reproductive success or fitness of the organism. Body size, pigmentation, swimming movement, behavior, and mortality were significantly altered in the experimental group. In the future, the study should be conducted over a longer time period in order to study the long-term effects of caffeine on the zebrafish development. These findings are important because they could extend to other organisms as well.
Lab #5 Invertebrates
February 15, 2015 - KB
Purpose
The purpose of this lab was to recognize the significance of invertebrates. The transformation of simpler systems into more complex systems through evolution was seen.
Materials and Methods
First, we observed three types of worms and recorded observations about their body structure and movement. Next, we picked out our Berlese Funnel, detached the tube, tossed the leaf litter in the trash, and cleaned out the funnel. We pipetted 10mLs of liquid and small particles from the tube onto two petri dishes. After locating small organisms and debris on the dishes, we made 5 wet mounts, and pipetted a small particle onto each one. Using a microscope, we observed the small organisms (all Arthropoda invertebrates) and identified them using an online dichotomous key. Finally, we considered the types of animals that trek through our transect and we categorized them by their phylum and put them into a food web.
Data and Observations
The acoleomate Planaria has a simple digestion system consisting of a mouth, pharynx, and gastrointestional cavity. Its simple movement looks like gliding and does not seem to take much effort. The nematodes, with their pseudocoelomate structure, is long and moves by squirming around rather than contracting and elongating its body. The coelomate Annelida seem to have ripples along its body and moves by contracting and elongating its body.
The organisms found in the Berlese Funnel were measured and observed:
The sizes range from 0.4 - 4 mm. The largest and most common organisms are the Arthropoda insecta, and the less common and smaller are the Arthropoda arachnida.
Vertebrates that may live in Tall Bushes: Warbler, Red-headed woodpecker, Rat, Garden Snake, Squirrel The short bushes would protect the rat and garden snake. The trees would provide shelter for the Warblers, woodpeckers, and squirrels. The soil mites, leaves, bacteria, and other species in the transect compose a biological community, or a group of different species in one habitat. The multiple species and their populations have carrying capacities, or limits of how many organisms in a population the ecosystem can sustain. Trophic levels are the positions that each organism occupies on the food chain. The producers in our transect would be the plants (short bushes and trees), the primary consumers would be the mites, bacteria, and the secondary consumers would be bigger vertebrates such as rats and birds.
Conclusions and Future Directions
This lab showed me the common types of invertebrates found in the transect tall bushes. From this data, we can further study our transect and the types of species and organisms that live in it.
Lab #4 Plantae and Fungi
February 3, 2015 - KB
Purpose
The purpose of this lab was to understand the characteristics, functions, and diversity of both plants and fungi. We were able to observe plants found in our transect and identify their structures, reproduction methods, and vascularization methods.
Materials and Methods
We began by exploring our transect and collecting samples. We collected leaf litter and five different plants. In our notebooks, we recorded the location and look of each plant. We created a Berlese Funnel from the leaf litter to prepare for the next week's lab. To get an idea about what different types of plants and fungi were characterized by, we examined several organisms under the microscope. This also taught us how to spot the presence of plant vascularization. Once we were familiar with the bryophytes and angiosperms, we began looking at our five plants under the microscope to characterize the vascularization. A cross section of each plant was made, examined, and data from the observation was recorded. Next, we examined the leaves from the samples from our transect to notice the presence of specialized structures. Next we looked for mechanisms of reproduction in our plants. We recorded whether the plant contained seeds, flowers, or spores.
Data and Observations
Transect 3: Tall Bushes
Transect Sample Plant #1
Located everywhere in our transect as ground cover. It is a short shrub, about a foot tall, that has an ovular, glossy green leaf. It is vascular with no specialized structures and no known seeds.
Transect Sample Plant #2
Located in the far east corner of our transect, a single bush was found. The leaves are almond shaped, glossy, and spiked. The plant is vascular. Specialized structures are berries and sharp tips. Reproduces by double fertilization due to presence of berries.
Transect Sample Plant #3
One tree was located in the north side of the transect. The leaves are small with spines. Three spikes are at the tip of each leaf. It is matte green. It is vascular and spikes are its specialized structures. No seeds or spores were found so mechanisms of reproduction are unknown.
Transect Sample Plant #4
One tree was found on the east side of the transect. The leaves are curvy, small, and contain spines. The leaf was spiked all around. It is vascular an specialized structures are it's sharp exterior. No seeds or spores were found so mechanisms of reproduction are unknown.
Transect Sample Plant #5
Three trees were found in the west sector of our transect. Each leaf had a rough surface texture and was a wide-almond shape. It had no spines. It was vascular and contains blooms are the tip of the stem. Due to the seeds, it can be affirmed that the plant uses double fertilization.
Conclusion and Future Directions
In conclusion, our transect contained a lot of vascular plants rather than fungi. The rough and spiky textures of the leaves suggest that it is difficult to grow there and mechanisms to provide protection are needed for the plants. The Berlese funnel will help to show what types of invertebrates thrive in this transect.
Lab #3 Microbiology and Identifying Bacteria with DNA Sequences
February 1, 2015 - KB
The purpose of this lab was to learn more about the identification and characteristics of bacteria. It also displayed the effects of antibiotic resistance. PCR was used to understand how DNA sequences are used to identify species.
Last week, we prepared serial dilutions. To do that, we obtained four nutrient agar plates and four tetracycline (antibiotic) plates; each plate was labelled. Each of the four plates were coated with different dilutions of the water in the hay infusions + sterile broths. Using micropipettors set at 100 microliters, we added the culture + mixed (each different dilution 10^-2, 10^-4, 10^-6, 10^-8) of broth to the plates. The agar plates then incubated in room temperature for a week. We observed our hay infusion culture: it's water level was much lower, it smelled less potent than a week ago, and the top film had disappeared. I attributed the water loss and nutrient loss to have killed many of the species in the jar. After that week, we gathered our agar plates and observed that bacteria had grown on each plate. We counted the amount of colonies (or a lawn) on each of the plates and recorded it on a table. Next, we made two wet mounts of the bacteria grown on the nutrient agar and tetracycline plates. We scraped up a bit of the colony, added it onto a slide along with a drop of water and coverslip on top. We then observed the slide under the microscope and recorded our findings. Our next procedure was the gram stains. On four labelled slides, we placed samples of TET bacteria 10^-5, TET bacteria 10^-7, Nutrient bacteria 10^-3, and Nutrient bacteria 10^-7. After adding a drop of water to each slide, we heated it by passing it under a flame 3 times. From there, we added crystal violet for 1 minute. Rinsed with water. Gram's iodine for 1 minute. Rinsed with water. 95% alcohol for 15 seconds. Safranin stain for 30 seconds. Rinsed with water. We blotted the extra water off then let the samples fully air dry. Then we looked at each slide under microscopes and recorded what we found. We then prepared a PCR for 16S sequencing. A single colony of bacteria was transferred to a 100 microliter water in a sterile tube and incubated at 100 celsius for 10 minutes, Then the sample was centrifuged for 5 minutes as 13,400 rpm. The supernatant was then added to a PCR tube mixed with 20 microliters of primer/water and added into the PCR machine. Next week we'll put it in an agarose gel and test for sequencing.
This is what the bacteria sample looked like from the Tetracycline agar under the microscope.
This is what the bacteria sample looked like from the Nutrient agar under the microscope.
These are what our agar plates looked like after a week of incubation in room temperature.
This is the chart of data collected by observing our agar plates. As you can see, the TET plates have much less growth than the nutrient plates. This suggests that some bacteria that are found on the nutrient plates are unable to grow on the antibiotic plates. The bacteria that can grow are resistant to the tetracycline.
This is our TET bacteria 10^-5 under the microscope at 10x. It is non motile, gram positive, purple and blue. It contains dots and large circular bacteria.
This is our TET bacteria 10^-7 under the microscope at 10x. It is non motile, gram negative, resembles orange and yellow colored shards of glass, and contains circular bacteria.
This is our Nutrient bacteria 10^-3 under the microscope at 10x. It is non motile, gram positive, purple, and resembles the texture of a broken fruit roll up.
This is our Nutrient bacteria 10^-7 under the microscope at 40x. It is non motile, gram negative, red and dark red, circular bacteria, and has a rough texture.
Our findings have led us to believe that our bacteria are greatly influenced by antibiotics, yet others are not. By looking at the gram stain, we can tell which of our bacteria contains the most peptidoglycan, which can further identify our bacteria. When we see the PCR results, we will be able to accurately identify our bacteria from our transect.
Lab #2 Identifying Algae and Protists
January 28, 2015 - KB
The purpose of this lab was to learn to differentiate the different types of protists and algae. We learned to identify the protists with the dichotomous key. The key classified unicellular organisms based on their size shape, movement, and color. I hypothesize that each of our hay infusion cultures from each transect will contain different organisms. To test this, we will take samples from our culture and identify the types of protists under the microscope.
I grabbed our hay infusion culture that was prepared last class. The culture contained microorganisms in each part of it. There were different organisms with different niches in each part of the culture. Since our jar consisted of different parts, we pipetted samples from the top and bottom. From the samples, we created wet mounts used for the microscope. We then identified and recorded three organisms from each part of the culture (top and bottom) using the dichotomous key.
When we observed our hay infusion culture which sat out for a week, it was clear that there were different ecosystems within the jar. The culture smelled moldy, stale, and pond-like. There was a dark green moldy, floating substance on the top. The middle section was greenish, yet transparent. There was a green mold that had settled on the bottom of the jar. Although we could not see anything moving with our naked eyes, we assumed there were living protists in the water and moldy substances.
The wet mount of the top was examined. Using the dichotomous key, we identified paramecium bursarla, which was motile and about 120 micrometers large. Next we found didinium, a stationary, unicellular protist around 80 micrometers. Lastly we found a motile green algae called pandorina that was 30 micrometers big. On the bottom sampled wet mount, we found paramecium aurelia, a motile, colorless 140 micrometer protist. Actinospharium, a green, 70 micrometer protist was also found. Finally, paramecium bursarla was also found on the bottom, yet it was smaller (80 micrometer) and still motile. All these organisms are living because they each require energy, are organized and complex, reproduce (asexually), and can grow.
The conclusions of this experiment clearly followed the purpose of the lab. We found a variety of protists and algae in our hay infusion cultures. The types of protists from the top and bottom wet mounts were different, suggesting that each ecosystem inside our jar required different types of protists. If this culture grew for another two months, we would most likely see most organisms due to meiosis and mitosis or we could see less organisms due to less resources the species need to survive.
Lab #1 Biological life at AU
January 25, 2015 - KB
The purpose of this lab was to observe an ecosystem. I was also required to collect a sample from the environment in that ecosystem. By observing a specific ecosystem, I am able to see the organisms and their niches in the community.
In this experiment, my partners and I were assigned a 20 m x 20 m transect (an ecosystem) called number 3: Tall bushes. We were required to draw a picture of our observations about the ecosystem. We found abiotic and biotic components of the section and labelled their location and identity. After perfecting our sketches and findings, we obtained a sterile 50 mL conical tube in which we placed a sample of soil/ ground vegetation from our transect. We returned to the classroom to perform a Hay Infusion Culture. We first took 10 g of our sample and placed it into a plastic jar filled with 500 mL of deerpark water. Next we added 0.1 g of dried milk, attached the lid of the plastic jar, and mixed the contents. Finally, the jar was labelled with our group name and placed on a table without the lid.
Our transect looked as followed:
My transect was labelled It is located in the center of campus, south of the amphitheater and east of the gymnasium. The section we are observing is flat. It is centered in an arboretum. It is an flat hourglass section, surrounded by sidewalks on all sides.
The components in transect 3 were: Abiotic Components: sidewalk, lamp post, snow Biotic Components: short shrubs, trees (deciduous), leaves, soil
This lab will lead me to find out more about my transect. The Hay Infusion Culture will display the types of organisms (protists) that make up transect 3. From there, we will be able to use a dichotomous key to find out the species and their niches in the community